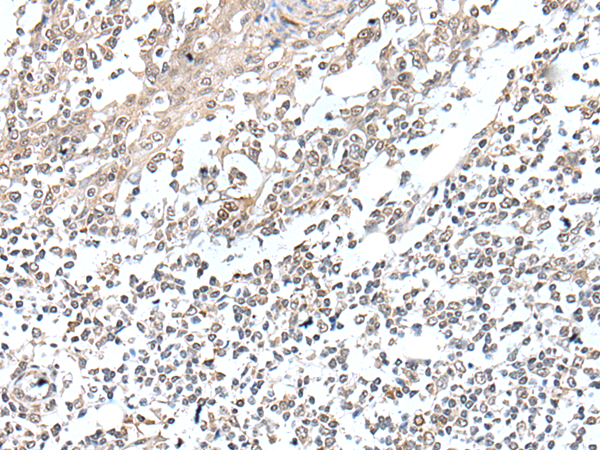

Background:
This gene encodes a protein with a transcriptional enhancer factor 1 (TEF-1) interaction domain. The encoded protein may act as a co-factor of TEF-1 regulated gene expression during skeletal muscle development. Alternatively spliced transcript variants encoding multiple isoforms have been observed.
Applications:
ELISA, IHC
Name of antibody:
VGLL2
Immunogen:
Full length fusion protein
Full name:
vestigial like family member 2
Synonyms:
VGL2; VITO1
SwissProt:
Q8N8G2
ELISA Recommended dilution:
5000-10000
IHC positive control:
Human colorectal cancer
IHC Recommend dilution:
25-100

購物車
幫助
021-54845833/15800441009
